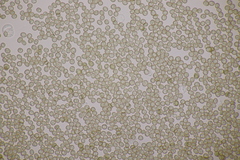
Ustilago filiformis
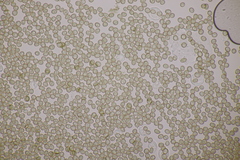
Ustilago filiformis

Ustilago filiformis: taxon details and analytics
- Domain
- Kingdom
- Fungi
- Phylum
- Basidiomycota
- Class
- Ustilaginomycetes
- Order
- Ustilaginales
- Family
- Ustilaginaceae
- Genus
- Ustilago
- Species
- Ustilago filiformis
- Scientific Name
- Ustilago filiformis
Summary description from Wikipedia:
Ustilago filiformis in languages:
- Bokmål
- søtgressot
- Finnish
- sorsimonnoki
- Swedish
- giftsot
Images from inaturalist.org observations:
We recommend you sign up for this excellent, free service.
Parent Taxon
Sibling Taxa
- Ustilago abaconensis
- Ustilago agropyri
- Ustilago agrostidis-palustris
- Ustilago airae-caespitosae
- Ustilago alopecurivora
- Ustilago aschersoniana
- Ustilago avenae
- Ustilago bethelii
- Ustilago bromina
- Ustilago bromivora
- Ustilago bullata
- Ustilago calamagrostidis
- Ustilago chloridis
- Ustilago circumdata
- Ustilago constantineanui
- Ustilago cynodontis
- Ustilago davisii
- Ustilago echinata
- Ustilago filiformis
- Ustilago grandis
- Ustilago hordei
- Ustilago jagei
- Ustilago lepturi-xerophili
- Ustilago neocopinata
- Ustilago nuda
- Ustilago panici-virgati
- Ustilago perennans
- Ustilago phrygica
- Ustilago residua
- Ustilago salweyi
- Ustilago scaura
- Ustilago scrobiculata
- Ustilago serpens
- Ustilago shiraiana
- Ustilago spinificis
- Ustilago sporoboli-indici
- Ustilago syntherismae
- Ustilago trichophora
- Ustilago tritici
- Ustilago utriculosa